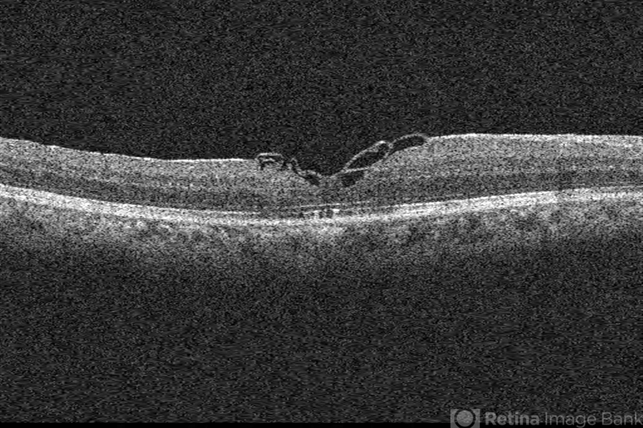

-
 By John S. King, MD
By John S. King, MD
Retina Associates, PA - Uploaded on Nov 6, 2019.
- Last modified by Caroline Bozell on Nov 7, 2019.
- Rating
- Appears in
- Miscellaneous
- Condition/keywords
- ILM flap, full thickness macular hole
- Imaging device
-
Optical coherence tomography system
Cirrus - Macular Scan - Description
- 68-year-old African American male with history of poor vision in the right eye, at least three weeks, was found to have a large macular hole (about 900 micron thickness), and VMT "hinge." Vision CF 2 ft with 1-2+ NSC. ILM was peeled and a petalloid type ILM flap was used along with viscoat to help keep tissue in place. 7 months later is 20/50 with a closed hole and residual, stringy like ILM remnants in the foveal region.

Initializing download.
Initializing download.





